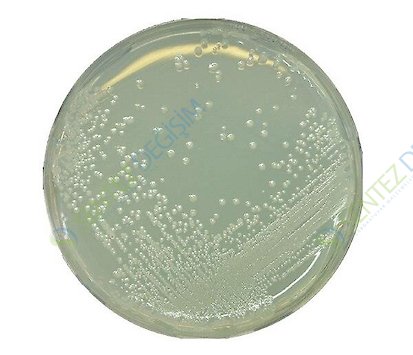
MERCK 107994.0500 Bat Agar For Microbiology

MERCK 107994.0500 Bat Agar For Microbiology
| Description |
|---|
| Catalogue Number | 107994 |
| Product Information |
|---|
| HS Code | 3821 00 00 |
| Quality Level | MQ200 |
| Safety Information according to GHS |
|---|
| Storage class | 10 - 13 Other liquids and solids |
| WGK | WGK 1 slightly hazardous to water |
| Storage and Shipping Information |
|---|
| Storage | Store at +15°C to +25°C. |
| Specifications |
|---|
| Appearance (clearness) | opalescent to turbid |
| Appearance (color) | yellowish |
| pH-value (25 °C) | 3.8 - 4.2 |
| Growth promotion test in accordance with the current version of IFU method no. 12 and DIN EN ISO 11133. |
| Inoculum on reference medium (Alicyclobacillus acidoterrestris DSM 2498) | |
| Inoculum on reference medium (Alicyclobacillus acidoterrestris DSM 3922) | |
| Inoculum on reference medium (Alicyclobacillus cycloheptanicus DSM 4006) | |
| Inoculum on reference medium (Alicyclobacillus hesperidum DSM 12766) | |
| Colony count (Alicyclobacillus acidoterrestris DSM 2498) | |
| Colony count (Alicyclobacillus acidoterrestris DSM 3922) | |
| Colony count (Alicyclobacillus cycloheptanicus DSM 4006) | |
| Colony count (Alicyclobacillus hesperidium DSM 12766) | |
| Recovery on test medium (Alicyclobacillus acidoterrestris DSM 2498) | ≥ 70 % |
| Recovery on test medium (Alicyclobacillus acidoterrestris DSM 3922) | ≥ 70 % |
| Recovery on test medium (Alicyclobacillus cycloheptanicus DSM 4006) | ≥ 70 % |
| Recovery on test medium (Alicyclobacillus hesperidium DSM 12766) | ≥ 70 % |
| Inoculum on reference medium (Alicyclobacillus acidoterrestris DSM 2498) | |
| Inoculum on reference medium (Alicyclobacillus acidoterrestris DSM 3922) | |
| Colony count (Alicyclobacillus acidoterrestris DSM 2498) | |
| Colony count (Alicyclobacillus acidoterrestris DSM 3922) | |
| Recovery on test medium (Alicyclobacillus acidoterrestris DSM 2498) | ≥ 70 % |
| Recovery on test medium (Alicyclobacillus acidoterrestris DSM 3922) | ≥ 70 % |
| Growth (Bacillus subtilis ATCC 6633 (WDCM 00003)) | total inhibition |
| Incubation:up to 5 days at 45 ± 1 °C aerobicA recovery rate of 70 % is equivalent to a productivity value of 0.7.The indicated colony counts result from the sum of a triple determination.Reference media: BAT agar |